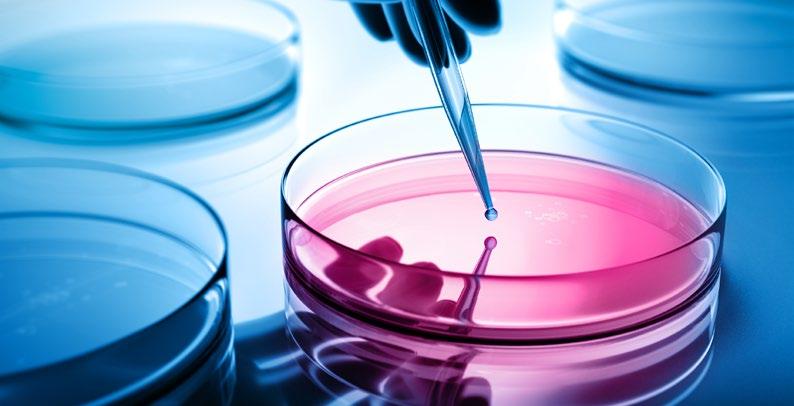
Cover for FAULHABER

7 minute read
FAULHABER
LA PRÉCISION POUR L’ANALYSE DES CELLULES
Quel traitement peut vaincre le cancer ? Quelle dose permet d’obtenir le résultat souhaité sans effets secondaires ? Au delà de quelle limite un médicament devient-il toxique ? On répond aujourd’hui à ces questions au moyen de séries de tests avec des cultures cellulaires. Il s’agit là d’une des principales méthodes utilisées dans la recherche médicale.
Advertisement
Le système de test automatisé CYRIS® FLOX facilite nettement le travail en laboratoire. Dans ce contexte, les moteurs de FAULHABER garantissent que les cultures sont alimentées en nourriture et en médicaments pendant toute la durée du test et que le développement des cellules est minutieusement surveillé, sans intervention humaine.
La limite de la viabilité
Sauver des vies, guérir des maladies, soulager des maux - c’est ce que font les médicaments modernes des millions de fois par jour. Mais il n’existe pas des remèdes à tous les maux. Par ailleurs, la Covid nous a nettement montré que de nouvelles maladies viennent constamment s’ajouter à celles que nous connaissons déjà. De nouveaux médicaments sont donc toujours nécessaires, et des travaux sont constamment effectués pour les développer. Ces médicaments doivent être aussi efficaces qu’ils sont sûrs - et ce, de préférence avant d’être testés sur l’homme. Bien que cette dernière phase, le test clinique, soit essentielle, il est aussi déjà possible d’en apprendre beaucoup sur l’effet d’un agent pharmaceutique en laboratoire, puisque celui-ci se déploie principalement dans les cellules du corps humain. Une culture cellulaire peut servir de substitut pour «essayer» le produit.
«Nous sommes par exemple en mesure de savoir à partir de quel seuil une substance devient toxique pour les cellules, explique Márton Nagy, développeur en biotechnologie de la société munichoise INCYTOИ®. D’ailleurs, cela ne s’applique pas qu’aux médicaments, mais aussi notamment aux polluants dans l’air. Nous introduisons une certaine quantité de la substance dans la solution nutritive contenant la culture et nous observons la réaction des cellules. Puis nous augmentons la quantité progressivement. Sur la base de données de mesure et d’un contrôle optique au microscope, nous pouvons identifier quand la situation devient critique. La quantité obtenue peut être convertie en poids corporel d’un être humain. Dans la pratique, on fixe généralement la limite autorisée pour une dose à une fraction de cette valeur critique.» Dans la recherche pharmaceutique, de nombreux tests sont effectués avec des cellules cancéreuses. Sauf qu’avec ces cellules, les rôles sont inversés : on cherche ici


à savoir quel médicament en quelle quantité inhibe leur prolifération ou les détruit complètement.
L’observation des cellules est un processus qui se fait à plusieurs niveaux et, surtout, qui prend pas mal de temps. Une seule expérience dure environ trois jours en moyenne. Pendant cette période, de nombreuses mesures individuelles sont faites et les cellules sont photographiées à intervalles rapprochés. Les séquences d’images peuvent être combinées en un film en accéléré et utilisées pour suivre le cours de la croissance cellulaire. Trois paramètres physiques sont examinés lors des mesures : la teneur en oxygène, la valeur du pH et la résistance électrique de la couche cellulaire.
Les quantités physiques fournissent des informations
Les valeurs de ces quantités sont influencées par le métabolisme des cellules. Par exemple, les cellules consomment plus d’oxygène lorsqu’elles sont en bonne santé que lorsqu’elles souffrent déjà de l’effet (secondaire) d’une substance introduite. La situation est similaire pour la valeur du pH : comme le métabolisme cellulaire produit des substances acides, le pH descend normalement vers la plage acide. Si cela se produit à un niveau moindre, le métabolisme est perturbé. Le degré de déviation permet de tirer des conclusions sur l’influence du médicament. Par ailleurs, la résistance électrique (impédance) augmente avec le nombre de cellules. Une montée retardée montre donc dans quelle mesure les cellules sont affectées.
Jusqu’à présent, de telles séries de tests nécessitaient beaucoup de travail manuel. Les différentes étapes n’avaient pu être que partiellement automatisées. Avec CYRIS® FLOX, INCYTOИ® a créé un dispositif entièrement automatisé qui peut effectuer le test sur plusieurs jours sans intervention humaine et, en même temps, complètement documenter les résultats. échantillons de cellules sont placés comme dans des boîtes de Petri miniatures. 24 pipettes au bout d’un bras robotisé alimentent les petites cultures en solution nutritive et introduisent les substances à tester. Chaque pipette peut contenir une composition différente de la solution. Chaque puits est équipé de capteurs qui mesurent teneur en oxygène, la valeur du pH et la résistance électrique. Ils sont tous photographiés par le bas à intervalles réguliers à travers une lentille de un microscope.
Développement pour l’automatisation
INCYTOИ® est une start-up aux racines académiques. Les fondateurs de l’entreprise travaillaient auparavant dans la recherche universitaire. C’est là qu’ils ont développé les premiers prototypes de leur appareil pour lesquels ils utilisaient des moteurs d’autres fabricants. Mais ces moteurs ne se sont pas avérés adaptés, ils ont été remplacés par des modèles de FAULHABER. Ces derniers ont su convaincre par leur design compact et la fiabilité de leurs composants. Ainsi, lorsqu’il s’est agi de poursuivre le développement pour la production en série, il n’a plus été nécessaire de chercher un fournisseur d’entraînement. Pourtant, de nouveaux objectifs ont été fixé dans ce contexte : «Nous voulions travailler avec le moins de types de moteurs différents possible, c’est ainsi que Matthias Moll, responsable du développement, décrit la situation initiale. Nous voulions également simplifier le câblage. Nous cherchions un entraînement dans lequel l’électronique était déjà intégrée. Jusqu’alors, elle était logée dans un élément de commande du bras du robot, ce qui nécessitait de nombreuses connexions de câbles dans un élément mobile.» En outre, les moteurs doivent pouvoir signaler les erreurs, par exemple lorsque la surchauffe provoque/menace de provoquer un blocage mécanique.
Combiné à un contrôleur de mouvement intégré de la série CxD, le servomoteur sans balais 2232...BX4 répond à ces nouvelles exigences des techniciens de INCYTOИ® ainsi qu’à toutes les autres, telles que des performances élevées dans un design extrêmement compact, un poids et un volume réduits, et la compatibilité avec les applications de


laboratoire. Six moteurs sont installés dans l’analyseur CYRIS® FLOX. Trois d’entre eux déplacent la tête de pipetage dans le bras du robot sur trois axes. Ils sont chargés de déplacer les pipettes avec précision sur les puits de microtitration et de les positionner juste au-dessus pour distribuer la solution. Un quatrième moteur entraîne 24 pistons d’aspiration qui transportent jusqu’à 200 µl du milieu de culture dans des embouts de pipette stériles. Deux moteurs déplacent le microscope sur une table XY située sous les échantillons de cellules. Les photos des différents puits sont prises par le bas à travers le matériau transparent des plaques de microtitration.
Précision et fiabilité en fonctionnement continu
«Afin de pouvoir suivre plus tard le développement des cellules individuelles en accéléré, la lentille doit toujours se trouver exactement au même endroit sous le puits, ajoute Matthias Moll pour expliquer le défi de cette étape. Avec l’aide des moteurs FAULHABER, nous pouvons positionner la table à deux micromètres près.» À titre de comparaison : un cheveu humain a une épaisseur de 50 à 70 micromètres. Le moteur qui entraîne les pistons de la tête des pipettes doit également fonctionner avec une extrême précision. Des résultats de tests valides ne peuvent être obtenus que si la quantité de liquide correspond exactement à celle qui est spécifiée. Pour l’automate CYRIS® FLOX, la précision est un impératif permanent. La maxime pour les applications motorisées est donc la répétabilité. Le mouvement exact doit être exécuté encore et encore à de courts intervalles, pendant toute la durée du test et sans déviation. «Nous attendons des entraînements qu’ils présentent le plus haut niveau de fiabilité possible en fonctionnement continu, souligne le responsable du développement. Ce n’est qu’alors que nous créerons les conditions nécessaires à un long «temps d’autonomie».» Dans le monde de l’automatisation des laboratoires, c’est le terme utilisé pour décrire le temps pendant lequel un test peut être réalisé sans intervention humaine. «Avec CYRIS® FLOX, ce temps peut être étendu de quelques minutes ou heures à plusieurs jours. En parallèle, les scientifiques hautement qualifiés et les techniciens de laboratoire peuvent effectuer d’autres travaux. L’efficacité des opérations de laboratoire augmente, les frais courants diminuent et l’appareil s’amortit très rapidement.»
https://www.faulhaber.com/nl/home/